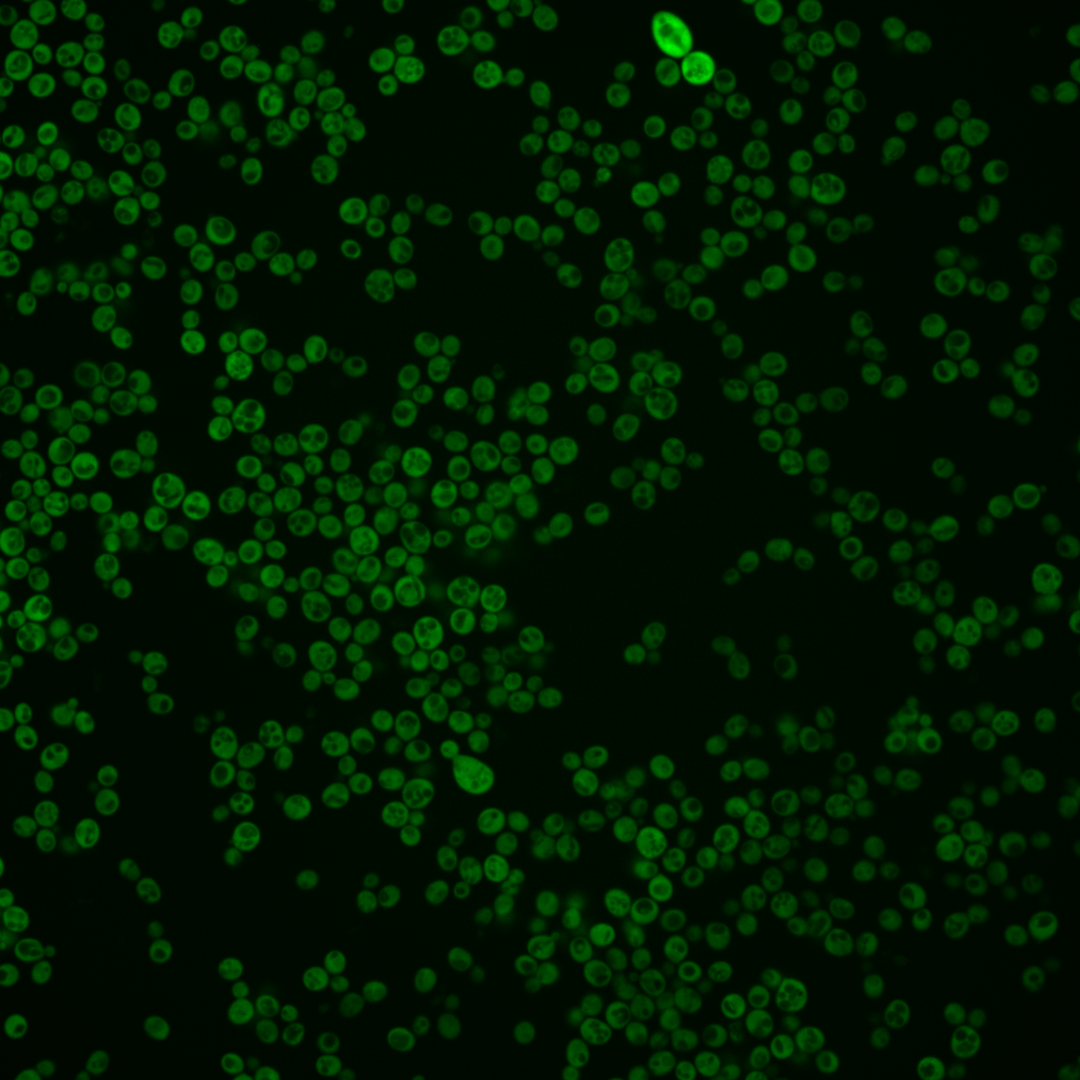
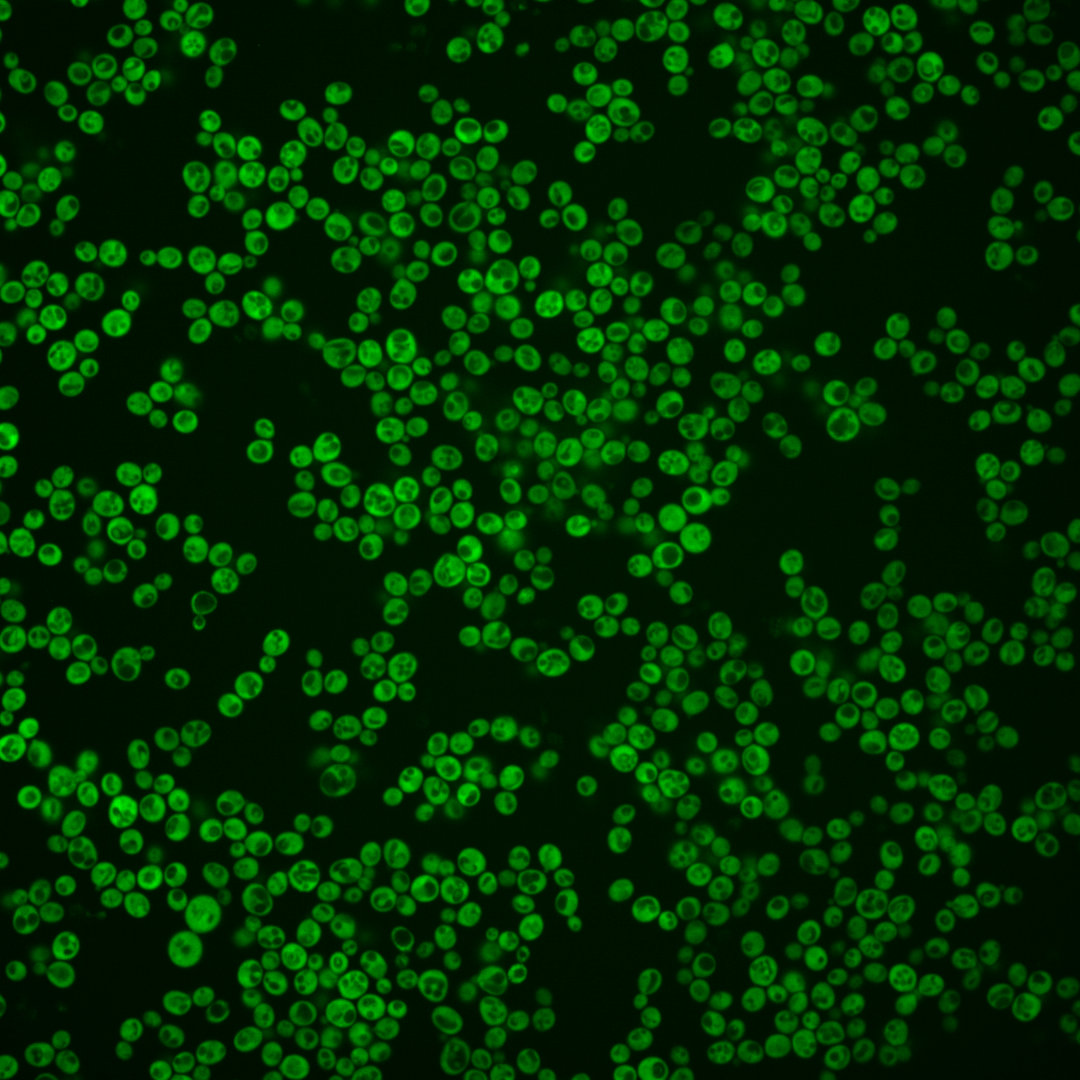
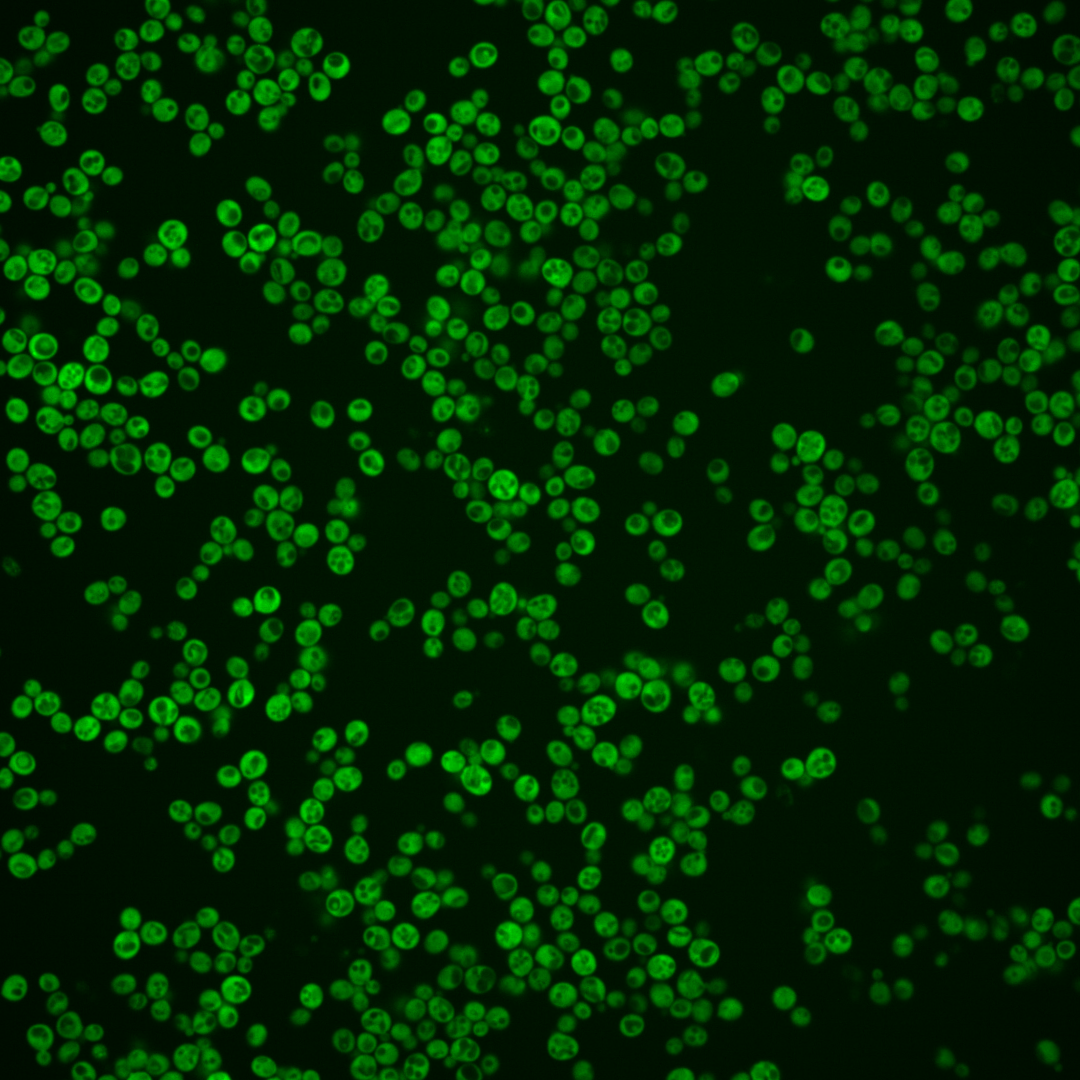
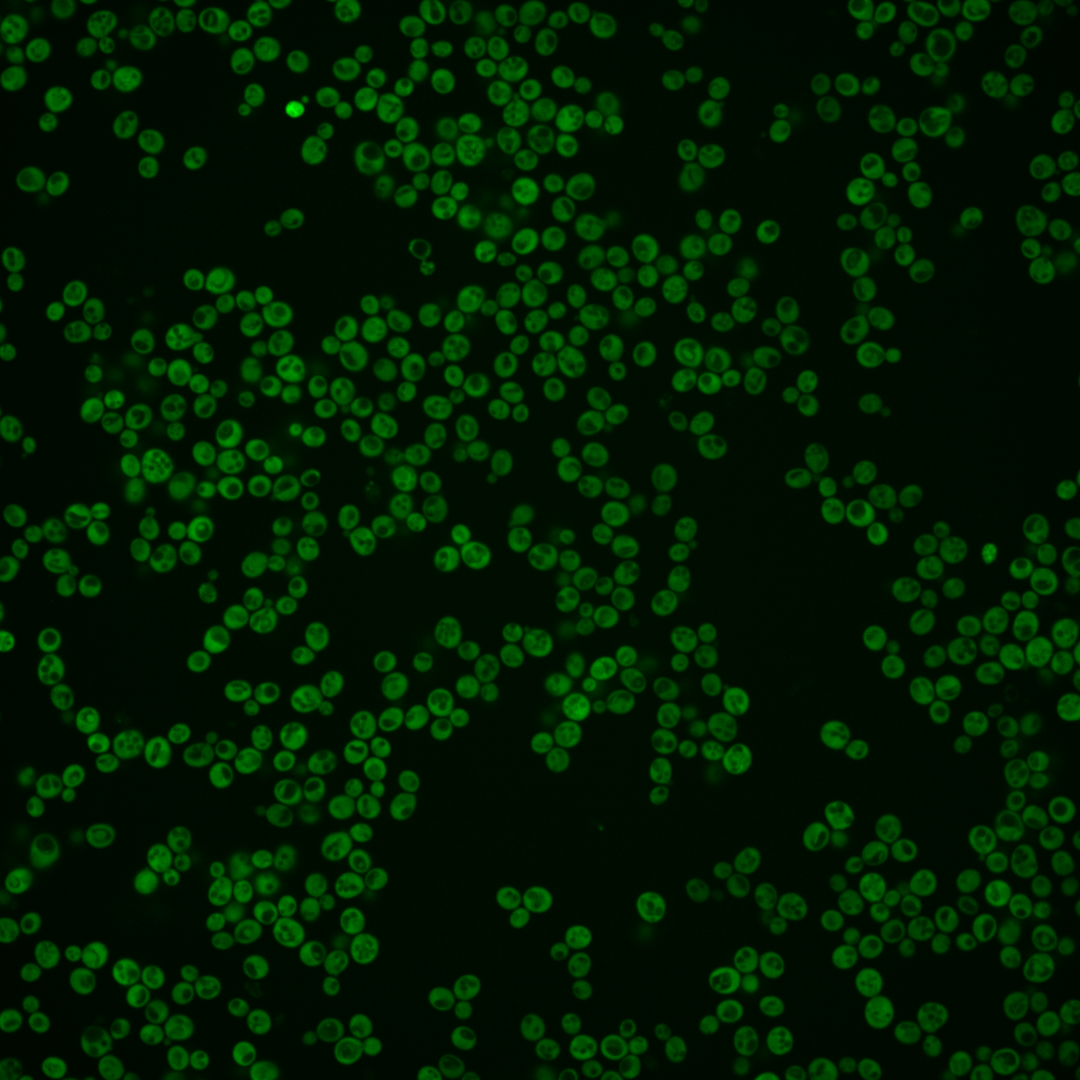
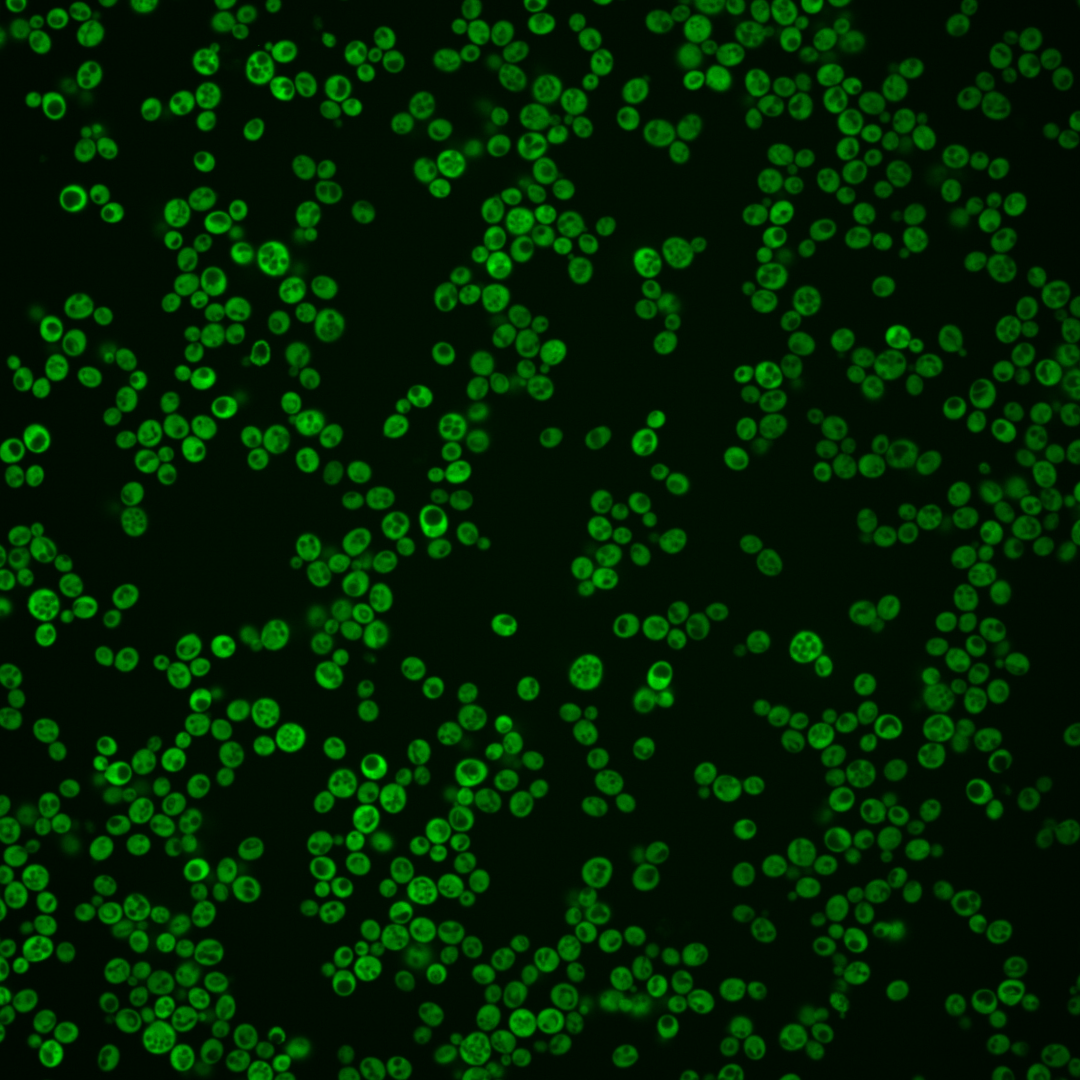
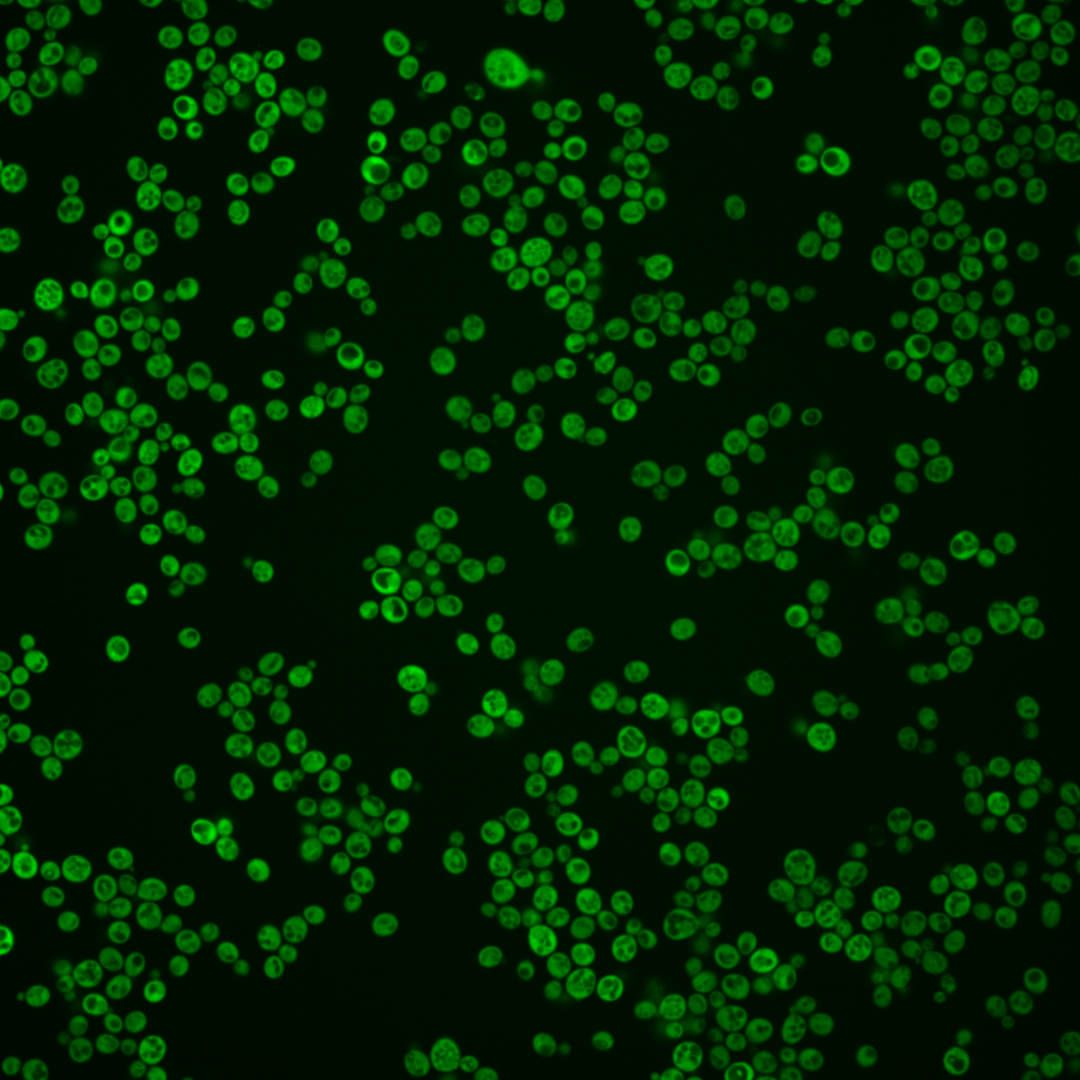
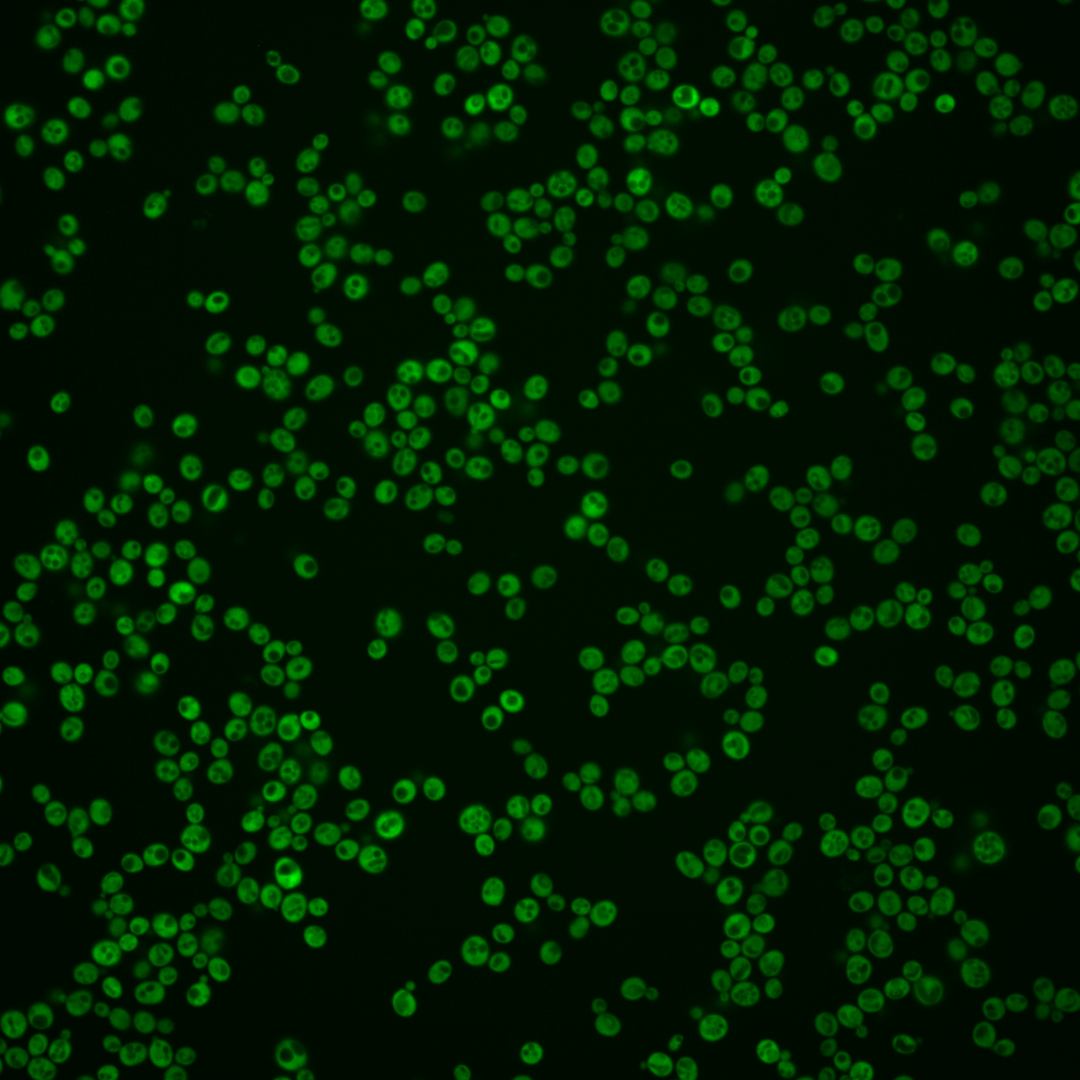

| Standard name | |
|---|---|
| Human Ortholog | |
| Description | Glucose-6-phosphate dehydrogenase (G6PD); catalyzes the first step of the pentose phosphate pathway; involved in adapting to oxidative stress; protein abundance increases in response to DNA replication stress; homolog of human G6PD which is deficient in patients with hemolytic anemia; human G6PD can complement yeast zwf1 null mutant |
Micrographs




















































































Sub-cellular Localization
Yeast GFP Assignment
Protein Abundance
Localization Change
External localization resources
| ensLOC | DeepLoc | |||||||||||||||||||||||
|---|---|---|---|---|---|---|---|---|---|---|---|---|---|---|---|---|---|---|---|---|---|---|---|---|
| Localization | WT1 | WT2 | WT3 | RAP60 | RAP140 | RAP220 | RAP300 | RAP380 | RAP460 | RAP540 | RAP620 | RAP700 | HU80 | HU120 | HU160 | rpd3Δ_1 | rpd3Δ_2 | rpd3Δ_3 | WT1 | WT2 | WT3 | AF100 | AF140 | AF180 |
| Cortical Patches | 0 | 0 | 0 | 0 | 1 | 1 | 4 | 7 | 5 | 3 | 5 | 7 | 0 | 0 | 0 | 0 | 0 | 0 | 0 | 0 | 1 | 0 | 0 | 0 |
| Bud | 1 | 4 | 2 | 0 | 0 | 2 | 1 | 1 | 3 | 4 | 1 | 2 | 1 | 1 | 0 | 0 | 0 | 0 | 0 | 0 | 0 | 0 | 0 | 1 |
| Bud Neck | 0 | 0 | 0 | 0 | 0 | 0 | 0 | 0 | 0 | 0 | 0 | 0 | 0 | 0 | 0 | 0 | 0 | 0 | 0 | 0 | 0 | 0 | 0 | 0 |
| Bud Site | 0 | 0 | 0 | 0 | 0 | 0 | 0 | 0 | 0 | 0 | 0 | 0 | 0 | 0 | 0 | 0 | 0 | 0 | – | – | – | – | – | – |
| Cell Periphery | 2 | 3 | 4 | 6 | 6 | 7 | 10 | 21 | 19 | 23 | 16 | 21 | 10 | 8 | 9 | 13 | 7 | 8 | 0 | 0 | 0 | 0 | 0 | 0 |
| Cytoplasm | 217 | 229 | 180 | 172 | 173 | 299 | 310 | 363 | 160 | 229 | 122 | 182 | 261 | 310 | 332 | 559 | 284 | 215 | 203 | 225 | 164 | 166 | 218 | 235 |
| Endoplasmic Reticulum | 1 | 2 | 0 | 6 | 0 | 8 | 21 | 56 | 15 | 25 | 6 | 17 | 3 | 1 | 2 | 26 | 13 | 5 | 0 | 1 | 3 | 3 | 1 | 6 |
| Endosome | 0 | 0 | 0 | 0 | 0 | 0 | 0 | 0 | 0 | 0 | 0 | 0 | 0 | 0 | 0 | 1 | 0 | 0 | 0 | 0 | 0 | 0 | 0 | 0 |
| Golgi | 0 | 0 | 0 | 0 | 0 | 0 | 0 | 0 | 1 | 0 | 1 | 0 | 0 | 0 | 0 | 0 | 0 | 0 | 0 | 0 | 0 | 0 | 0 | 1 |
| Mitochondria | 1 | 0 | 0 | 0 | 0 | 1 | 7 | 8 | 9 | 21 | 16 | 20 | 0 | 0 | 0 | 4 | 2 | 0 | 0 | 0 | 0 | 0 | 0 | 1 |
| Nucleus | 0 | 1 | 0 | 2 | 0 | 0 | 2 | 0 | 0 | 2 | 0 | 0 | 0 | 0 | 0 | 1 | 0 | 0 | 0 | 0 | 2 | 0 | 0 | 0 |
| Nuclear Periphery | 0 | 0 | 0 | 0 | 0 | 0 | 0 | 1 | 0 | 0 | 1 | 0 | 0 | 0 | 0 | 0 | 0 | 0 | 1 | 0 | 0 | 0 | 1 | 0 |
| Nucleolus | 0 | 0 | 0 | 0 | 0 | 0 | 0 | 0 | 0 | 0 | 0 | 0 | 0 | 0 | 0 | 0 | 0 | 0 | 0 | 0 | 0 | 0 | 0 | 0 |
| Peroxisomes | 0 | 0 | 0 | 0 | 0 | 0 | 0 | 0 | 0 | 0 | 0 | 0 | 0 | 0 | 0 | 0 | 0 | 0 | 0 | 0 | 0 | 0 | 0 | 0 |
| SpindlePole | 0 | 0 | 0 | 0 | 0 | 0 | 0 | 0 | 0 | 0 | 0 | 0 | 0 | 0 | 0 | 0 | 0 | 0 | 0 | 0 | 0 | 0 | 0 | 0 |
| Vac/Vac Membrane | 0 | 0 | 0 | 0 | 2 | 1 | 8 | 13 | 4 | 8 | 4 | 6 | 0 | 1 | 0 | 1 | 0 | 0 | 0 | 1 | 3 | 0 | 0 | 1 |
| Unique Cell Count | 218 | 232 | 181 | 178 | 177 | 310 | 353 | 442 | 198 | 286 | 155 | 229 | 262 | 312 | 336 | 563 | 286 | 219 | 208 | 230 | 178 | 174 | 229 | 255 |
| Labelled Cell Count | 222 | 239 | 186 | 186 | 182 | 319 | 363 | 470 | 216 | 315 | 172 | 255 | 275 | 321 | 343 | 605 | 306 | 228 | 208 | 230 | 178 | 174 | 229 | 255 |
Yeast GFP Assignment
Protein Abundance
| Screen | WT1 | WT2 | WT3 | RAP60 | RAP140 | RAP220 | RAP300 | RAP380 | RAP460 | RAP540 | RAP620 | RAP700 | HU80 | HU120 | HU160 | rpd3Δ_1 | rpd3Δ_2 | rpd3Δ_3 | AF100 | AF140 | AF180 |
|---|---|---|---|---|---|---|---|---|---|---|---|---|---|---|---|---|---|---|---|---|---|
| Mean Cell GFP Intensity (1e-4) | 24.4 | 25.0 | 18.6 | 18.4 | 19.2 | 18.7 | 16.4 | 17.0 | 15.7 | 15.4 | 14.3 | 15.4 | 36.2 | 42.4 | 46.3 | 37.0 | 48.3 | 52.1 | 24.5 | 23.3 | 26.9 |
| Std Deviation (1e-4) | 4.3 | 4.9 | 4.4 | 3.8 | 4.0 | 3.6 | 3.8 | 3.9 | 4.3 | 4.5 | 4.2 | 4.6 | 8.2 | 10.3 | 11.1 | 10.5 | 13.6 | 12.7 | 5.6 | 6.1 | 7.0 |
| Intensity Change (Log2) | – | – | – | -0.01 | 0.05 | 0.01 | -0.18 | -0.13 | -0.24 | -0.27 | -0.37 | -0.27 | 0.96 | 1.19 | 1.32 | 0.99 | 1.38 | 1.49 | 0.4 | 0.33 | 0.53 |
Localization Change
| Localization | RAP60 | RAP140 | RAP220 | RAP300 | RAP380 | RAP460 | RAP540 | RAP620 | RAP700 | HU80 | HU120 | HU160 | rpd3Δ_1 | rpd3Δ_2 | rpd3Δ_3 |
|---|---|---|---|---|---|---|---|---|---|---|---|---|---|---|---|
| Cortical Patches | 0 | 0 | 0 | 0 | 0 | 0 | 0 | 0 | 0 | 0 | 0 | 0 | 0 | 0 | 0 |
| Bud | 0 | 0 | 0 | 0 | 0 | 0 | 0 | 0 | 0 | 0 | 0 | 0 | 0 | 0 | 0 |
| Bud Neck | 0 | 0 | 0 | 0 | 0 | 0 | 0 | 0 | 0 | 0 | 0 | 0 | 0 | 0 | 0 |
| Bud Site | 0 | 0 | 0 | 0 | 0 | 0 | 0 | 0 | 0 | 0 | 0 | 0 | 0 | 0 | 0 |
| Cell Periphery | 0 | 0 | 0 | 0 | 1.5 | 3.0 | 2.6 | 3.1 | 2.9 | 1.0 | 0 | 0 | 0 | 0 | 0.8 |
| Cytoplasm | -1.9 | -1.4 | -2.1 | -4.6 | -5.9 | -6.0 | -6.2 | -6.3 | -6.2 | 0.3 | -0.1 | -0.7 | -0.2 | -0.2 | -1.1 |
| Endoplasmic Reticulum | 0 | 0 | 0 | 3.3 | 5.0 | 3.8 | 4.1 | 0 | 3.7 | 0 | 0 | 0 | 2.9 | 2.9 | 0 |
| Endosome | 0 | 0 | 0 | 0 | 0 | 0 | 0 | 0 | 0 | 0 | 0 | 0 | 0 | 0 | 0 |
| Golgi | 0 | 0 | 0 | 0 | 0 | 0 | 0 | 0 | 0 | 0 | 0 | 0 | 0 | 0 | 0 |
| Mitochondria | 0 | 0 | 0 | 0 | 0 | 0 | 3.7 | 4.4 | 4.1 | 0 | 0 | 0 | 0 | 0 | 0 |
| Nucleus | 0 | 0 | 0 | 0 | 0 | 0 | 0 | 0 | 0 | 0 | 0 | 0 | 0 | 0 | 0 |
| Nuclear Periphery | 0 | 0 | 0 | 0 | 0 | 0 | 0 | 0 | 0 | 0 | 0 | 0 | 0 | 0 | 0 |
| Nucleolus | 0 | 0 | 0 | 0 | 0 | 0 | 0 | 0 | 0 | 0 | 0 | 0 | 0 | 0 | 0 |
| Peroxisomes | 0 | 0 | 0 | 0 | 0 | 0 | 0 | 0 | 0 | 0 | 0 | 0 | 0 | 0 | 0 |
| SpindlePole | 0 | 0 | 0 | 0 | 0 | 0 | 0 | 0 | 0 | 0 | 0 | 0 | 0 | 0 | 0 |
| Vacuole | 0 | 0 | 0 | 0 | 0 | 0 | 0 | 0 | 0 | 0 | 0 | 0 | 0 | 0 | 0 |
External localization resources
Images






























Protein Concentration and Protein Localization Data
| R1 | R2 | R3 | ||||||||||||||||
|---|---|---|---|---|---|---|---|---|---|---|---|---|---|---|---|---|---|---|
| G1 Pre-START | G1 Post-START | S/G2 | Metaphase | Anaphase | Telophase | G1 Pre-START | G1 Post-START | S/G2 | Metaphase | Anaphase | Telophase | G1 Pre-START | G1 Post-START | S/G2 | Metaphase | Anaphase | Telophase | |
| Concentration | 25.8781 | 39.1047 | 35.9762 | 38.6535 | 37.038 | 35.2714 | 26.6716 | 35.3166 | 30.4212 | 28.1023 | 28.5834 | 31.0973 | 27.8382 | 39.8264 | 35.1988 | 32.483 | 34.6962 | 33.9046 |
| Actin | 0.021 | 0.0004 | 0.0002 | 0.0015 | 0.003 | 0.0013 | 0.014 | 0.0026 | 0.001 | 0.0426 | 0.0217 | 0.003 | 0.014 | 0.0001 | 0.0147 | 0.0004 | 0.0002 | 0.0003 |
| Bud | 0.0007 | 0.0006 | 0.0006 | 0.0014 | 0.0003 | 0.0002 | 0.0003 | 0.0002 | 0.0002 | 0.0008 | 0.0006 | 0.0002 | 0.0003 | 0 | 0.0008 | 0.0001 | 0.0001 | 0 |
| Bud Neck | 0.0013 | 0.0002 | 0.0003 | 0.0006 | 0.0003 | 0.0013 | 0.0003 | 0.0001 | 0.0002 | 0.0003 | 0.0002 | 0.0008 | 0.0006 | 0.0001 | 0.0003 | 0.0002 | 0.0003 | 0.0003 |
| Bud Periphery | 0.0007 | 0.0001 | 0.0006 | 0.0033 | 0.0005 | 0.0001 | 0.0006 | 0.0002 | 0.0002 | 0.0011 | 0.0008 | 0.0001 | 0.0003 | 0 | 0.0009 | 0.0001 | 0 | 0 |
| Bud Site | 0.0079 | 0.0014 | 0.0001 | 0.0003 | 0.0005 | 0.0001 | 0.0008 | 0.0019 | 0.0004 | 0.0026 | 0.0005 | 0.0002 | 0.0008 | 0 | 0.0005 | 0 | 0 | 0 |
| Cell Periphery | 0.0006 | 0.0002 | 0.0002 | 0.0017 | 0.0005 | 0 | 0.0001 | 0.0001 | 0.0001 | 0.0001 | 0.0001 | 0 | 0.0002 | 0 | 0.0001 | 0 | 0 | 0 |
| Cytoplasm | 0.778 | 0.9915 | 0.9846 | 0.9006 | 0.9008 | 0.9675 | 0.9252 | 0.9821 | 0.9545 | 0.8956 | 0.905 | 0.9679 | 0.8352 | 0.9984 | 0.9491 | 0.9366 | 0.9953 | 0.9799 |
| Cytoplasmic Foci | 0.0428 | 0.001 | 0.0004 | 0.0004 | 0.0038 | 0.0009 | 0.0091 | 0.0009 | 0.0069 | 0.0025 | 0.0046 | 0.0053 | 0.0321 | 0.0001 | 0.0019 | 0.0005 | 0.0009 | 0.0022 |
| Eisosomes | 0.0004 | 0 | 0 | 0.0001 | 0.0004 | 0.0001 | 0.0003 | 0 | 0 | 0.0001 | 0.0002 | 0 | 0.0001 | 0 | 0 | 0 | 0 | 0 |
| Endoplasmic Reticulum | 0.0064 | 0.0004 | 0.0007 | 0.0007 | 0.0042 | 0.0027 | 0.003 | 0.0002 | 0.0026 | 0.0008 | 0.0014 | 0.0031 | 0.0032 | 0.0001 | 0.0012 | 0.0009 | 0.0002 | 0.0003 |
| Endosome | 0.0182 | 0.0001 | 0.0007 | 0.0011 | 0.0023 | 0.0013 | 0.0087 | 0.0004 | 0.0097 | 0.0332 | 0.0158 | 0.0064 | 0.022 | 0 | 0.003 | 0.0018 | 0.0002 | 0.0005 |
| Golgi | 0.002 | 0 | 0 | 0.0003 | 0.0004 | 0.0003 | 0.0039 | 0.0006 | 0.0011 | 0.0025 | 0.0067 | 0.0027 | 0.0093 | 0 | 0.0005 | 0.0013 | 0 | 0.0002 |
| Lipid Particles | 0.0094 | 0.0001 | 0 | 0.0004 | 0.0049 | 0.0007 | 0.0057 | 0.0003 | 0.003 | 0.0014 | 0.0035 | 0.0039 | 0.0182 | 0 | 0.0004 | 0.0001 | 0 | 0.0036 |
| Mitochondria | 0.008 | 0.0002 | 0.0001 | 0.0364 | 0.0111 | 0.0082 | 0.0033 | 0.0085 | 0.0041 | 0.001 | 0.0215 | 0.001 | 0.0039 | 0 | 0.012 | 0.0538 | 0 | 0.0002 |
| None | 0.0114 | 0.0005 | 0.0001 | 0.0002 | 0.0143 | 0.0004 | 0.0061 | 0.0001 | 0.0021 | 0.0002 | 0.0026 | 0.0004 | 0.0101 | 0.0001 | 0.0004 | 0.0001 | 0.0002 | 0.0001 |
| Nuclear Periphery | 0.0236 | 0.0005 | 0.0017 | 0.0027 | 0.0225 | 0.0051 | 0.0062 | 0.0002 | 0.0019 | 0.0009 | 0.0039 | 0.0008 | 0.0042 | 0.0001 | 0.0023 | 0.0012 | 0.0004 | 0.0003 |
| Nucleolus | 0.0035 | 0.0001 | 0 | 0.0009 | 0.0047 | 0.0009 | 0.0002 | 0.0001 | 0.0002 | 0.0002 | 0.0002 | 0 | 0.0008 | 0 | 0.001 | 0 | 0 | 0 |
| Nucleus | 0.0206 | 0.0011 | 0.0024 | 0.005 | 0.0123 | 0.0058 | 0.0064 | 0.0007 | 0.0015 | 0.0012 | 0.0019 | 0.0014 | 0.0053 | 0.0007 | 0.0057 | 0.0017 | 0.002 | 0.0011 |
| Peroxisomes | 0.0021 | 0 | 0 | 0.0003 | 0.0006 | 0.0001 | 0.0025 | 0.0005 | 0.004 | 0.0005 | 0.004 | 0.0015 | 0.013 | 0 | 0.0006 | 0.0001 | 0 | 0.0106 |
| Punctate Nuclear | 0.0207 | 0 | 0 | 0 | 0.003 | 0.0007 | 0.0015 | 0 | 0.0005 | 0.0001 | 0.0017 | 0.0004 | 0.0225 | 0 | 0.0002 | 0 | 0.0001 | 0.0001 |
| Vacuole | 0.0158 | 0.0013 | 0.0062 | 0.0127 | 0.0041 | 0.0012 | 0.0014 | 0.0002 | 0.0042 | 0.0105 | 0.0019 | 0.0007 | 0.003 | 0 | 0.0025 | 0.0005 | 0.0001 | 0.0001 |
| Vacuole Periphery | 0.0049 | 0.0002 | 0.001 | 0.0295 | 0.0057 | 0.001 | 0.0006 | 0.0001 | 0.0017 | 0.0017 | 0.0014 | 0.0003 | 0.001 | 0 | 0.0016 | 0.0006 | 0 | 0.0001 |
Sequencing Data
| R1 | R2 | |||||||||
|---|---|---|---|---|---|---|---|---|---|---|
| G1 Post-START | S/G2 | Metaphase | Anaphase | Telophase | G1 Post-START | S/G2 | Metaphase | Anaphase | Telophase | |
| Gene Expression | 143.5589 | 112.4131 | 172.1346 | 165.6431 | 104.1388 | 154.0133 | 146.0179 | 159.413 | 225.7958 | 128.3 |
| Translational Efficiency | 0.8946 | 0.8409 | 0.9112 | 1.4383 | 1.0349 | 1.0864 | 0.904 | 1.2042 | 0.9997 | 0.9052 |
Hit Data
| Dataset | Hit |
|---|---|
| Protein Concentration | ✘ |
| Protein Localization | ✘ |
| Gene Expression | ✘ |
| Translational Efficiency | ✘ |
Endocytosis
| Temp | Actin Patch (Sac6-tdTomato) | Cortical Patch (Sla1-GFP) | Late Endosome (Snf7-GFP) | Vacuole (Vph1-GFP) |
|---|---|---|---|---|
| 37℃ | ||||
| RT |
Cell Cycle Omics
CYCLoPs (Zwf1-GFP)
| Gene / Allele | Actin Patch (Sac6-tdTomato) | Cortical Patch (Sla1-GFP) | Late Endosome (Snf7-GFP) | Vacuole (Sac6-tdTomato) |
|---|
| Gene | Images |
|---|
| Gene | Images |
|---|
Images are not yet available
Images are not yet available